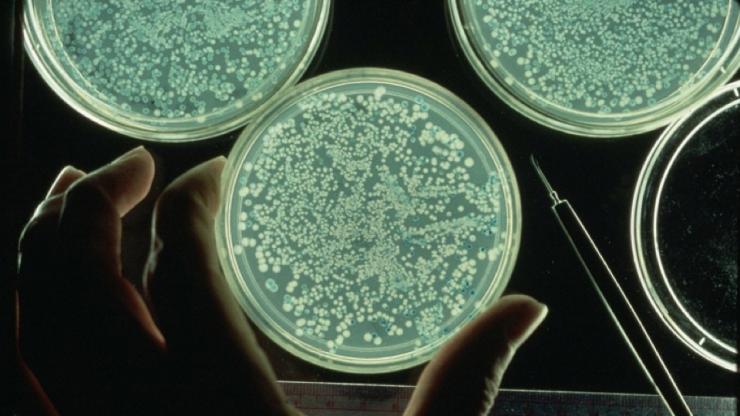
Human Microbiome Research

Positioned to Lead
Baylor College of Medicine is uniquely positioned to lead in bringing discoveries made in the laboratory to patients. Several years ago, College leadership recognized that resources and infrastructure were necessary to facilitate this process. Therefore, the College has made and continues to make significant investments to provide the foundation necessary. A few of these are highlighted below.
Shared Resources

The Advanced Technology Cores were established in 2010 to provide access to cutting-edge technology and training for all researchers at the College.
The Dan L. Duncan Institute for Clinical and Translational Research (ICTR) opened in 2010. The ICTR has regulatory, research support and informatics teams that support and promote translational and clinical research efforts across the College and partner institutions.
Collaborative Centers of Excellence
Centers create dynamic environments for collaborations across traditional scientific divides.
A Collaborative Center in Action
In 2011, Baylor launched the Alkek Center for Metagenetics and Microbiome Research to apply the expertise it amassed as one of three sequencing centers of the Human Genome Project to the Human Microbiome Project, which sequences microbes that inhabit the human body. The center has led to hundreds of collaborations in this field with huge potential upsides in both diagnostics and therapeutics. Work in this area led to a strategic partnership between Baylor Genetics and Diversigen, both commercial endeavors of the College, that provides their respective customers with a broad range of microbiome and metagenomics services, as well as targeted genomics and metabolomics services.
Strategic Research Centers
Other centers developed over the last few years with a specific view to supporting the movement of research out of the laboratory to benefit patients include the:
Therapeutic Innovation Center
Center for Neuroscience and Artificial Intelligence
Memory Brain Research Center
Center for Translational Research on Inflammatory Diseases
Cardiovascular Research Institute
Center for Drug Discovery
Center for Precision Environmental Health
The College also invested in growing collaborations in cancer research, which contributed to the success of the Dan L Duncan Comprehensive Cancer Center in obtaining designation as a comprehensive center from the National Cancer Center.
Licensing

The aim of commercialization at the College is to maximize the impact of our research enterprise by supporting the development and commercialization of the College’s intellectual property assets into products and services that benefit the public, and to foster the development of a culture of entrepreneurship where commercialization is viewed as a natural extension of the College’s research activities.
Recruitment and Retention
The College’s single most important resource for ensuring discoveries are made and applied to improve human health is its human capital. Growing the Baylor advantage depends on recruiting and retaining experts in informatics, early-stage clinical research and medicinal chemistry while continuing to add individuals with strengths across basic and clinical science disciplines.
Our recruiting processes attract diverse professionals from around the world. Once at Baylor, we focus on engaging our faculty as research demonstrates that engaged faculty are more likely to remain at their institution and are more productive. The College participates in the AAMC StandPoint Engagement Surveys. Baylor faculty consistently rate their satisfaction with the College, their departments, and their peers higher than faculty at other academic medical centers that participate in this initiative.
Keep up with the latest scientific advances as we bring scientific discoveries from the laboratory to the patient. Read the latest news from Baylor, visit our department and center websites, and find faculty who share your interests.